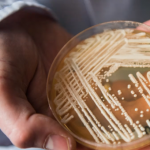

Yuan, Li
视频:21岁男子向约克区民宅6秒连开18枪被捕
【星岛都市网】一名 21 岁男子涉嫌去年 11 月在约克区向民宅开出至少18枪,他被控多项罪名。
案发于去年11月3日晚上约 11 时,于安省Georgina的Danny Wheeler Boulevard 近Valleo Street一间住宅。
警方发布的影片显示,一名疑犯站在路中间,向房屋连续开枪,然后乘坐一辆 SUV 逃离现场,疑犯在六秒钟内似乎开了约18枪。
警察到场时发现二楼卧室的窗户被打碎,卧室内有弹孔,他们在房子前面的车道和街道上发现数个弹壳。
约克警方确认与该事件有关的其中一名疑犯。
警方对多伦多居民 Vishaal Suthagar 提出多项指控,包括故意开枪和未遵守保释条件,这些指控尚未经过法庭证实。
一名疑犯仍然在逃,警方没有提供有关其余疑犯的任何详细资讯。
警方发新闻稿表示,案件具针对性,当局正继续调查。
(图:约克区警方)T11
特朗普强执法南下加人担忧 移民律师建议赴美改搭飞机
【星岛都市网】一位移民律师表示,自从美国特朗普政府以执法为导向的政策生效以来,有更多关于加拿大人在边境被拘留或绿卡持有者被安置在驱逐中心的报告。
据1130 News报道,华盛顿州布莱恩(Blaine)的律师伦桑德斯(Len Saunders)表示,这些说法可能会让加拿大人感到不安,因为过去几周前往边境以南的车流明显减少。
桑德斯表示:“从拜登政府的低执行力到特朗普政府的执法力度,钟摆似乎已经发生了很大的摆动。”他认为这可能成为未来4年的趋势,而特朗普上任才两个月。
边境官员搜查手机的情况并不罕见。然而,桑德斯建议,展望未来,如果人们打算开车越过边境,应该仔细检查他们设备上的内容。
他说:“普通加拿大人不是恐怖分子,也不是图谋不轨,但很多人可能不支持特朗普。他们的社群媒体上可能有这样的讯息,他们可能会担心。我不认为你会因此而被拒绝入境。”
他认为,网络上分享的一些经历,包括穆尼(Jasmine Mooney)在美墨边境申请工作许可证时被拘留两周的案例,正在导致加拿大人重新考虑未来前往美国的旅行计划。
如果必须入境美国而有所担心的话,桑德斯建议从加拿大飞往美国,而不是开车。
他说:“你可以要求立即离开。当你通过美国移民局时,加拿大皇家骑警总是坐在那里。所以,如果你感觉不舒服或想离开温哥华机场,你可以随时从美国海关处离开。”
(图:加通社资料图片)
V11
多伦多市议员自行投票决议加薪 薪酬将超$17万
【星岛都市网】多伦多市议会,昨(27日)晚上投票通过市议员加薪24%。
昨晚市议会以15比8票,通过加薪建议,市议员的薪酬将由逾13万加至超过17万。
根据市政职员报告,加薪令市府在2025年的薪酬及福利支出,增加接近100万。
市长邹至蕙昨晚没有出席投票,她也不受加薪影响,她之前曾表示认为加薪幅度太多,认为应该由第三方决定是否加人工。
预算委员会主席高雪莉认为加薪是合理调整,表示之前几届市府都延迟加薪。
(图:资料图片)T11
特朗普与卡尼谈话称极有成效 改口风“尊”称总理 相约大选后见面
【星岛都市网】加拿大总理卡尼今早与特朗普通电话,是两国领袖第一次通话。卡尼昨天向记者表示,特朗普的办公室已与他们接触和安排通话。
卡尼今天也将与各省长和地区首长视频会面,商讨如何应对关税美国总统特朗普早前签署行政命令,向进口汽车及汽车零件征收25%关税。
特朗普与卡尼通话后,于其社交平台《Truth Social》上发文,表示谈话极有成效,并透露在多方面达成共识,他还表示将在“加拿大即将举行的大选之后”立即与卡尼会面,讨论对“两国”都有利的议题,而此前他曾多次暗示美国应该吞并加拿大,使其成为其中一个州份。
特朗普早前多次称呼前总理杜鲁多为“州长”,今日文中一改以往的称呼,称卡尼为“总理”。
卡尼尚未公开回应。
(图:加通社)T11
惊爆!卡尼被指控牛津博士论文涉嫌抄袭 三学者发现10处未注明部分!
【星岛都市网】据《国家邮报》报道,联邦自由党领袖马克·卡尼在竞选活动期间被指控将他人的想法据为己有。这一问题并不是首次被提及。
据悉《国家邮报》获得了一份卡尼 1995 年在牛津大学完成经济学博士的论文《竞争的动态优势》(“The Dynamic Advantage of Competition”)副本。根据三位审阅过该材料的大学学者的判断,他们发现该论文有 10 处明显抄袭之处。
在论文的多个部分中,卡尼直接引用、改写或稍作修改后使用了四部前人著作的作品,却没有适当标注或注明出处。
“他直接重复没有加引号。这就是我们所说的剽窃,”负责处理大学剽窃案件的 UBC 校长学生纪律咨询委员会成员、助理教授Geoffrey Sigalet说。
被指控有问题的部分段落对比:
“The setting for the game is a pure exchange economy with a finite...
宾顿市四车相撞涉警车 SIU介入调查
【星岛都市网】宾顿市昨(27日)发生连环交通意外,至少有一辆警车被卷入其中,SIU介入调查。
皮尔区警方表示,案发于下午近4时半,Mississauga Road 夹Steeles Avenue共有四辆车卷入交通意外。
两人受伤被送往医院,没有生命危险,目前尚未清楚伤者中是否有警察。
警方特别调查组(SIU)已介入此案,警方并未提供更多有关事故发生情况的细节。
特别调查局(SIU)是一个独立的政府机构,负责调查可能导致死亡、重伤、性侵犯和/或向他人开枪的警员行为。
(图:City News)T11
美国网红“甲亢哥”开启中国行 京沪直播6小时数百万网友观看
【星岛都市网】美国网红“甲亢哥”近日首次开启中国行,他连续在京沪等地开启6小时直播,吸引全球数百万网友观看。镜头中他坐中国高铁、参观故宫长城、试驾小米电车,中国驻美大使馆评论称,数码世界具影响力人士正弥合文化差距。
中国使馆:数码世界正弥合文化差距
“甲亢哥”IShowSpeed甲亢哥原名小达伦·沃特金斯(Darren Watkins Jr.),在YouTube拥有3720万粉丝,因其风格夸张,长时间处于“亢奋”状况,被中国网民称为“甲亢哥”。
甲亢哥和中国大妈互动。 直播画面
甲亢哥在中国。 直播画面
甲亢哥在中国。 直播画面
甲亢哥在中国。 直播画面
甲亢哥在中国。 直播画面
3月24日“甲亢哥”来到上海,到人民公园相亲角与几位大妈聊天,与歌手王嘉尔进行乒乓球对决,还看了舞狮、少林功夫和川剧变脸。夜游外滩时,他惊叹“第一次见到这么美的城市”。
3月26日他转战北京,参观故宫和长城,试穿老北京布鞋,还品尝了豆汁、爆肚等特色美食。次日他首次乘坐了中国高铁,网友们发现即使列车在隧道中行驶,直播也没有出现卡顿。据悉未来长达半个月的旅程中,他还将去西安看兵马俑,去成都看大熊猫。
中国驻华盛顿大使馆周三(26日)在社交平台X发文称,“甲亢哥”之行表明在数码世界具有影响力人士正在弥合文化差距,为外国观众了解充满活力的中国创造新渠道。
多伦多球迷因戴“加拿大不卖”帽子被赶出体育场!蓝鸟队代表道歉!
【星岛都市网】安省怡陶碧谷居民Dan Begley本应在周四下午和他的两个朋友在罗杰斯中心观看蓝鸟队的主场揭幕战。然而这位老球迷表示,由于他佩戴的帽子,他在比赛开始后不久就被“两名高大的保安护送出了体育场”。
在昨日的比赛中,现年70岁的Begley身穿蓝鸟队的连帽衫,头戴一顶红色棒球帽,上面写着“加拿大不卖”。
今年早些时候,在美国总统特朗普开始威胁要对加拿大商品征收新关税后不久,安省省长福特在首次省长会议上戴的就是这种帽子。福特说,他戴这顶帽子是为了提醒所有加拿大人“捍卫我们的国家”的重要性。
相关阅读:省长福特戴的帽子引发热卖 两小时销售额$2万!巨企总裁也买了
Begley大约两周前得到了这顶帽子,他说他觉得这个信息引起了他的共鸣,并决定戴着它去看今天的比赛。
“我喜欢这句话,我觉得应该有更多的人为加拿大挺身而出,提高意识,”他周四晚上告诉CP24。
“它只写了加拿大不卖,而且上面还有一面加拿大国旗。”
Begley说,他从没想过这顶帽子会有什么问题,他说他实际上在体育场里呆了大约一个半小时,并补充说,给他上啤酒的酒保甚至还称赞了他。
然而,不久之后,一名引座员走过来礼貌地告诉他,他戴的帽子违反了他们“禁止发表政治言论的规定”。
他说,他被告知,要么把帽子转过来戴,要么就把它摘下。
Begley说:“我怀疑他们是不希望它出现在电视上或大屏幕上。”并补充说他觉得自己被要求做的事情是“错误的”,所以拒绝配合。
随后,两名保安和一名主管走近他,把他带到一个大厅,然后把他带出了体育场。
“我在出去的路上大喊,我想让大家知道我被赶出去是因为我戴了这顶帽子……他们一直重复说他们只是在遵守规定,”Begley谈到“相当尴尬的局面”时说道。
“我支持了我的国家,但却觉得自己像个罪犯。这件事毁了整个活动。”
Begley说,他随后乘坐GO火车回了家。
他决定联系媒体,因为他觉得其他人应该了解这个所谓的有争议的标志政策。
“我想要一个道歉,否则我所有关于蓝鸟队的东西都会被扔进垃圾袋。”他还说,这不是钱的问题,而是政策的问题,他希望看到改变。
“我希望能够坐在那里支持我的国家,而不必担心被赶出去。”
周四下午晚些时候,CP24联系了多伦多蓝鸟队,请其就此事发表评论。发言人Andrea Goldstein在一封电子邮件中写道:“我们已经与这位粉丝通话并向其表示歉意。”
“我们的工作人员犯了一个错误,我们已经解决了这个问题,以确保不再发生这种情况。”
Goldstein说,他们已经邀请Begley回到体育场,“他已经接受了我们的道歉,并期待着回来。”
Begley在后续采访中证实,他与一名蓝鸟队的代表进行了交谈,该代表为所发生的事情道歉,并为他提供了另一场比赛的免费门票。
他说,他们还告诉他,戴着“加拿大不卖”的帽子去体育场是可以的。
“发生这种事真是太糟糕了。有人真的失去了判断力。这是不对的,”Begley说。
“我对妻子说,‘蓝鸟队的比赛让人很紧张,’但事情本不该是这样的。”
编译:YUAN
图片:视频截图、CP24
麦当劳新推枫糖早餐三宝 烟熏甜香一次满足!
【星岛都市网】喜欢McGriddles的人注意,加拿大麦当劳又有新作!
早餐系列加入100%加拿大枫糖浆,推出全新“Smoky Maple”为你每日的早晨注入浓浓的甜香。
三款新作包括烟熏枫糖培根蛋汉堡、烟熏枫糖炸鸡汉堡,以及烟熏枫糖香肠蛋McGriddles,甜咸交织,令早餐一秒升级。
凡选购早餐套餐可配薯饼与咖啡,需要留意的是,枫糖系列只限早上11点前供应,并不包含于全日早餐之中,所以想尝试的朋友记得早起。
目前此系列已于全国参与分店限时供应,售完即止。无论你喜欢甜、喜欢烟熏、还是喜欢试新品,这个春天去麦当劳享受一个甜蜜早餐吧!
(图:加拿大麦当劳)T11
市中心凌晨工业意外 电力工人触电身亡
【星岛都市网】多伦多市中心今(28日)凌晨发生工业意外。
案发于凌晨近2时,于Queens Quay West 夹Rees,发生工业意外,电力工人在水库工作时触电身亡。
警方指,一名30多岁男子受重伤被送院治理,随后被宣布死亡。
另一人受伤接受治疗,情况稳定。
安省劳工厅正调查事件。
(图:City News)T11
冰暴今晚来袭!大多伦多地区发布冻雨警告
【星岛都市网】冰暴即将来临,Durham区和约克区已经发布冻雨警告,可能带来高达 10 毫米的冰层。
加拿大环境部于今(28日)向多伦多、万锦市、旺市、烈治文山市、密西沙加市等发出警示,表示今晚至明早及明晚至星期日早上可能会有冻雨。
降雨将在今日稍后开始,然后转为冻雨,但由于预计气温将在冰点附近波动,因此周六有可能再次降雨。
积冰厚度很可能达到 10 毫米,可能会造成停电,道路会结冰而湿滑。
气象学家 Jill Taylor 表示,多伦多和大多伦多仍处于特殊天气预报之中,周六早晨和周日早晨可能会再次出现冻雨。
Taylor表示,风暴系统也会受到温度的影响。到目前为止,多伦多地区早晨的最低气温接近或略高于冰点,多伦多仍可能持续降雨。
加拿大环境部表示,多伦多及其周边地区仍可能发布冻雨警告。
安省警长克里·施密特(Kerry Schmidt)说,周末的天气状况可能会使大多伦多地区的驾驶条件变得十分危险。
施密特在社交媒体上发布的一段视频中说:“雨水接触地面后会结冰,并会粘在你的车辆表面、道路你停车的树上。”
“如果冰层堆积得足够多,树枝可能会掉下对你的车辆造成损害。这也可能导致停电,所以你可能需要为今晚、明天和整个周末储备一些必需品。”
2013 年 12 月,一场冰暴袭击了大多伦多地区,冰层厚度超过 30 毫米,并造成了大面积停电。
相关阅读:环境部警告!周五起多伦多或遭遇“强春季冰暴” 持续四天!
(图:加通社)T11
总理卡尼暂停竞选活动 处理美国关税威胁问题
【星岛都市网】总理兼联邦自由党党魁卡尼,继续暂停竞选活动,先处理美国关税威胁问题。
加拿大广播电台引述消息指,卡尼今早会与特朗普通话,为两国领袖第一次通话。卡尼昨日向记者表示,特朗普的办公室已接触他们及安排通话,报道又指,卡尼今早的公开日程空白,在竞选期间并不常见。
卡尼今日亦会与各省长及地区首长视频会面,商讨如何应对关税。
加通社报道,美国总统特朗普早前宣布,下星期三向进口汽车及汽车零件征收25%关税后,昨日部份车厂的股价下跌。
而另外两名主要联邦政党的党魁则继续竞选活动。
联邦新民主党党魁驵勉诚,今日会在多伦多宣布事项,联邦保守党党魁博励治,亦会在卑诗省纳奈莫开记者会。早前驵勉诚表示,一旦当选,会采取多项措施支援加拿大汽车业,博励治就在活动上,呼吁特朗普停止关税。
加新社报道,最近民调显示,选民最关心的议题,是哪一个领袖在面对特朗普经济威胁的时候,最能捍卫加拿大利益。
(图:加通社)T11
UBC科学家发明特殊搅拌棒 可检测饮料是否被掺药
【星岛都市网】卑诗大学(UBC)的研究人员表示,他们正准备开始对一款搅拌棒进行“实际测试”,这款特殊的搅拌棒可以检测饮料中是否有掺药。
该大学在新闻稿中表示,这种名为“Spikeless”的设备是在其应用科学学院开发的,发明者希望广泛采用,以打击饮料中添加药物并防止性侵犯。
新闻稿说,这款“看似普通的搅拌棒”可以检测GHB(约会强暴药)和氯胺酮(俗称K他命)等毒品,如果饮料被掺药,颜色就会改变。
卑诗大学硕士生、共同发明者尤素菲(Samin Yousefi)表示,与类似的发明相比,例如用于检测含药饮料的杯子、杯垫或吸管,这种搅拌棒“很谨慎”。
校方表示,这项发明的概念是由化学和生物工程副教授福斯特(Johan Foster)和他的兄弟于2011年提出的,原型在过去3年一直在研展中。
福斯特表示,如果搅拌棒让顾客感到更安全,它可以为酒吧和其他地方提供潜在的“竞争优势”。
加拿大各地警方多次就含药饮料发出警告,卑诗省那乃磨市的皇家骑警在收到“几宗”社区夜总会饮料被下药的报案后,于本月发起了一场唤起公众意识活动。
(图:加通社/HO-UBC Applied Science Communications & Marketing)
V11
加国男足世界排名创新高 戴维斯受伤需休养数月教练被骂
【星岛都市网】刚在周日夺得中北美洲及加勒比海国家联赛(CONCACAF Nations League)季军的加拿大男子足球国家队,世界排名跃升至第30位,创历史新高;但队长兼拜仁慕尼黑戴维斯(Alphonso Davies)膝盖韧带严重受损,需休养数月,加军教练马斯(Jesse Marsch)因此受到批评。
根据国际足协(FIFA)最新公布的排名,加拿大跃升一位,首次挤身30强榜单,排名高过波兰、塞尔维亚等欧洲国家,也凌驾尼日利亚、科特迪瓦和喀麦隆等非洲劲旅,但在北美仍然包尾,被美国(第16位)和墨西哥(第17位)抛离。
戴维斯在周日力挫美国队的季军战中早段伤出,赛后拜仁证实他膝盖韧带撕裂,需养伤数月,将会错过余下的德甲和欧联球季,以至在6 、7月间举行的世界球会冠军杯赛事。
戴维斯的经理人霍塞(Nedal Huoseh)周三发声明批评马斯疏忽,导致戴维斯蒙受不必要伤患。霍塞指责马斯在球员并非处于最佳状态的情况下,仍逼使其正选上阵。
加拿大足总(Canada Soccer)同日发声明回应,强调国家队的教练团及医疗团队均为真正专业人员,并总是将球员的安全及福祉置于优先考虑,“任何否定此说的言论均非属实”。
View this post on Instagram
A post shared by OneSoccer (@onesoccer)
图:CBC
V20
震惊!穿Rogers制服人员向住户汽车撒尿 公司将其解雇并洗车赔罪
【星岛都市网】卑诗省鲑鱼湾(Salmon Arm)居民斯洛斯(Stephen Slous)周五(21日)在观看监控拍下的即时影像时,他以为有人在光天化日下想盗窃他的汽车,但结果使他感到吃惊。
据CTV报道,事发时斯劳斯一家正身在外地度假,突然接到手机发信息通知,家门外有访客。
他立即查看监控画面,看见一名身穿电讯商罗杰士(Rogers)制服的男子按了门铃,然后等了大约30秒后步离。但他没有真正离开,而是走到了车库。
斯洛斯说:“他向着我的车撒尿,然后若无其事地走开。”
斯洛斯呆了半晌才能接受眼前所见景象,他说:我实在不能相信有人会认为那是可以‘方便’的合适场所。”
视频显示,一柱液体从汽车的轮胎上溅起,并在车道上留下一滩尿迹。
罗杰士其后表示,画面中的男子是一名并非由该公司直接雇用的销售员。
该公司的发言人表示:“当我们知悉这宗涉及第三方承包商的事件时,已立即采取措施解决问题。该名人员已不再受雇于相关的供应商,我们已联系受影响的户主并就此表示歉意。”
斯洛斯说,罗杰士表示愿意代他支付洗车和清洗车库所需的费用。
图:Stephen Slous
V20
加拿大卫生部全国招聘助理 应征者不需要大学学位
【星岛都市网】加拿大卫生部正在全国招聘办公室助理。该职位不需要大学学位或大专院校院的文凭。
这些工作机会遍及温哥华、维多利亚、卡尔加里、埃德蒙顿、里贾纳(Regina)、萨斯卡通、温尼伯(Winnipeg)、多伦多、金斯顿、渥太华、蒙特利尔、魁北克市、蒙克顿(Moncton)、哈利法克斯等地,如果被录用,将在加拿大卫生部企业服务部门担任高级专案支援医疗办公室助理。
该工作是作为联邦政府雇员的医疗服务提供者,年薪自62,533加元至67,699加元。居住在加拿大的人、身在海外的加拿大公民和永久居民都可以申请。
征聘条件是必须完成两年高中学业并拥有以下经验:
提供行政支援
使用电子资讯或记录系统
处理和保护敏感资讯
分析、处理和回应客户的请求
应征者需要具备英语或法语的口头和书面沟通能力。但有些职位可能要求懂英法双语。
这些工作必须在办公室工作,可接受临时通知要加班、出差,双手可以举起和搬运重达44磅的物品,以及亲自为客户提供服务。
拥有大专院校的医疗办公室助理证书或文凭,曾在医疗诊所或医疗办公室担任助理的经验可被视为加分。
这些职位的申请截止日期是加东时间3月31日晚上11时59分。
(图:加通社资料图片)
V11
多伦多天气油价汇率 今日有雨最高6度
【星岛都市网】多伦多今晨天气油价汇率资讯
2025年3月28日星期五,农历二月廿九;
多伦多今日天气:多云,下午有雨
最高温度6度,最低温度0度
今晨外汇即时行情:
1加元兑换美元0.70美元
1加元兑换人民币5.07元
今日油价:
大多地区加油站平均油价范围报156.9分/升。
股市:
S&P/TSX昨收 25,161.06,0.00 (0.00%)
DOW昨收 42,299.70;-155.09 (-0.37%)
上证综指收于3351.75;-22.44 (-0.67%)
深证成指收于10607.33;-60.77 (-0.57%)
图片:资料图
突发!英王查尔斯癌症治疗后出现副作用住院
【星岛都市网】白金汉宫称,英国国王查尔斯因接受预定的癌症治疗出现 “暂时性副作用”,于周四入院接受观察。
他原定于周四下午和周五的活动已被取消。
白金汉宫表示:“国王陛下现已返回克拉伦斯宫,作为预防措施,根据医嘱,明天的日程也将重新安排。国王陛下向所有因此而感到不便或失望的人们致歉。”
T03 图片:美联社
多伦多皮尔逊机场发生安全事件 部分航班延误!
【星岛都市网】据《星报》报道,周四上午,多伦多皮尔逊机场发生一起 “安全事件”,导致部分航班延误。
加拿大航空运输安全局在一封电子邮件中表示,在安检人员对一件行李进行适当检查之前,该行李就被送还给了乘客。
未被检查的行李立即被发现并与乘客一起被找到。经过重新安检后,未发现任何令人担忧的物品。
机场媒体发言人Sean Davidson在给《星报》的一封电子邮件中说,事件发生在 1 号航站楼的跨境区域。
邮件中说,情况已经得到解决,运营已恢复正常。
建议乘客向其航空公司查询航班状态。
T03 图片:资料图
可致命抗药菌正以惊人速度传播 加拿大已证实65例!
【星岛都市网】一种名为耳念珠菌(Candida auris)的超级细菌正在以“惊人的速度”在医院和疗养院传播,美国疾病控制及预防中心(CDC) 最近称其为紧急的抗药性病菌威胁。
据Global News报道,CDC上周发出警告,称耳念珠菌的威胁日益增加,因为它不仅对多种抗真菌药物具有高度抗药性,而且还能耐受医院常用消毒剂。
声明中写道:“CDC已将耳念珠菌视为紧急的抗生素抗药性(AR)威胁,因为它通常对多种抗真菌药物具有抗药性,很容易在医疗机构中传播,并可能导致严重感染和高死亡率。”
这种担忧不仅限于美国。自2009年在日本首次发现这种病原体以来,它已在世界各地传播,在医院和长期护理院(包括加拿大)引发了长期且具有挑战性的疫情爆发。
安省公共卫生部门1月时正式将这种真菌病原体标记为“具有公共卫生意义的疾病”。这意味着它现在被认为是一种公卫风险,需要密切监测,并采取措施预防和控制其传播。
埃德蒙顿的微生物学家、新兴病原体专家泰特罗(Jason Tetro)说:“耳念珠菌是一种酵母菌,它是皮肤上的正常定殖者,基本上可以放任它,不会对你造成伤害。但如果它碰巧进入粘膜区域或碰巧进入你的血液,它可能会引起感染,从而导致严重的问题。”
他说,感染者的死亡率可能高达50%至60%。泰特罗强调,这种病原体对于免疫系统受损的人来说尤其危险。
即使患者存活下来,他们在治疗后仍可能被真菌定殖数年,并有可能在毫无戒心的情况下将其传播下去。这种真菌还可以在人与人之间传播,并在床栏、门把手和医疗设备等表面存活,可能持续数周,许多清洁工并无法杀死它。
泰特罗说:“大多数酵母菌都有一个外壳,可以保护它们免受许多不同类型的清洁剂的侵害,所以除非你使用过氧化氢或漂白剂,否则真的一事无成。”
3月17日发表在《美国感染控制杂志》 (American Journal of Infection Control)上的一项研究调查了佛州医院环境中耳念珠菌的生长情况。研究发现,从2019到2023年,这种真菌“迅速增加”。
临床培养物的数量逐年增加,从2019年的5个增加到2020年的29个、2021年的71个、2022年的107个和2023年的115个。研究称,所有采样的培养物都对一种名为氟康唑的常见抗真菌治疗具有抗药性。
据加拿大公共卫生局(PHAC)称,自2012年发现第一例耳念珠菌个案以来,截至2025年3月26日,当局已收到共65宗耳念珠菌病例报告。
尽管耳念珠菌对全球人类健康构成严重威胁,但泰特罗认为,透过适当的监测、检测和严格的感染控制措施,可以控制其传播。
(图:美联社资料图片)
V11
多伦多7大必试日式拉面 品尝地道美味!
【星岛都市网】作为汇聚全球美食的国际城市,多伦多的拉面文化早已发展成熟,无论是浓郁醇厚的豚骨汤、清爽的鱼介汤,还是融合创意的新派风味,都可以吃到最地道的日式美味!从传统日式职人手艺到独具匠心的本地创新,这 7 间人气拉面店绝对值得一试,带你感受舌尖上的极致满足!
Musoshin Ramen
Musoshin Ramen是来自京都的高人气拉面店,以火炙五花叉烧与浓郁的素食蔬菜汤底闻名,没有传统加入豚肉的油腻感,其面条亦是每日新鲜自家制作,尤为推荐Ajitama Musoshin拉面,它以五日发酵味噌搭配浓厚猪肉汤,风味十足!
除此以外,面店提供主厨Aoi Yoshida的独家烘焙料理。Aoi Yoshida在京都牛奶农场长大,在当地曾开设一家日式甜品店“Hollyhock Japanese Sweets”。她把家乡的味道带来多伦多,其中一道招牌甜品“草莓麻薯”,糯米的外表包里着红豆馅和新鲜草莓,吃起来却出奇地轻盈,深受客人喜爱。
价钱︰$20-30
地址:9 Boustead Ave, Toronto, ON
Ramen Buta-Nibo
Ramen Buta-Nibo是多伦多首家二郎系拉面,而二郎拉面来自东京着名的 “拉面二郎”,其特色是份量十足、面条厚实、汤汁浓稠、豆芽和高丽菜成堆,配上厚厚的猪肉片。多伦多这间面店同样主打超大份量的粗幼面,配上叉烧、椰菜、豆芽和蒜泥,加以浓厚豚骨汤,吃一碗超满足!
价钱︰$20-30
地址:547 Danforth Ave, Toronto, ON
Touhenboku Ramen
Touhenboku Ramen提供来自九州的浓郁豚骨拉面,汤底奶白浓稠,配上厚实叉烧,让人一试难忘!它同时提供日式慢煮鸡汤汤底,可选择配以厚豚肉、瘦肉或鸡肉,味道浓郁又不会过于油腻。除了传统口味,还有泡菜拉面、酸辣拉面等创新选择。
店主Zuimei 曾在千叶著名的拉面学校Shokuno...
卡尼预计很快与特朗普首次通话!承诺将反击汽车关税
【星岛都市网】美国总统特朗普对非美国制造的汽车和轻型卡车征收25%的关税,预计将成为竞选活动第5天各党领导人关注的焦点。
自由党领袖马克·卡尼原定今天在魁北克进行竞选活动,但他取消了行程,前往渥太华与加美关系委员会开会,讨论加拿大对汽车关税的回应。
保守党领袖博励治目前在卑诗省,新民主党领袖驵勉诚则在安大略省竞选。
卡尼在渥太华发表讲话称,加拿大将对美国的汽车关税采取报复性贸易行动。这一应对措施将“对美国产生最大影响”,对加拿大的影响最小。
他补充说,政府将保护工人,建立一个新的加拿大经济。
卡尼说,特朗普针对汽车行业征收“不合理的”关税,违反了加拿大和美国之间现有的贸易协定。
“我理解并尊重他支持美国工人的目标,但我不同意他认为这是帮助他们的方式,”卡尼说,并补充说,关税最终将损害美国工人和消费者的利益。
“我反对任何削弱加拿大的企图。”
卡尼表示,特朗普昨晚联系了他,希望安排一次通话。如果通话成功,这将是两国元首之间的首次通话。卡尼表示将和特朗普总统在“未来一两天”进行会谈。
他指出,虽然电话会议将重点关注4月2日即将到来的美国汽车关税,但预计当天还会有一系列其他关税。
卡尼说,一旦这些情况变得更加明朗——可能就在当天——“我们将能够做出更全面的回应。”
他重申了他希望与美国谈判的两个条件:“首先,尊重我们作为一个国家的主权。这个要求并不高,但对特朗普来说显然很高。”卡尼还表示,他希望与总统就经济和安全问题进行“全面讨论”。
当被问及如果美国关税生效,加拿大下周将如何回应时,卡尼不愿透露细节。
“这是一次谈判,”他说,并补充说,政府将在一周内了解“更多信息”。“在谈判中,暴露自己的秘密是没有意义的。”
卡尼指出,威胁征收的关税适用于所有国家,而不仅限于加拿大和墨西哥,他说:“我想说的是,我们得到了一份糟糕协议中的最好协议。”
更多的对等关税将于4月2日出台,包括对林业、木材、制药和半导体等行业的关税。
“我们可以采取一些措施来响应这些举措。”
当被问及政府是否会考虑对出口到美国的石油和天然气征收报复性关税时,卡尼说:“我们有很多选择。我们将明智地使用它们。”
“这是一场谈判。行动的时候就要行动,不要预先承诺。”
T03 图片:CP24
加拿大明天发放残疾福利金 这些人合资格
【星岛都市网】明天(28日)将发放加拿大联邦政府残疾福利金,金额将按申请人的情况而定。
根据政府网站资料,申请人须证明健康状况与军警服务相关。合资格申请人包括加拿大军人或退伍军人、现任或前任皇家骑警(RCMP)成员,以及二战或韩战退伍军人。二战期间因敌方行动而受伤的平民亦符合申请资格。
福利金分为两种形式,包括终身每月付款或一次性赔偿的“痛苦及损失赔偿”,金额介乎$69.6至$1,391.98;以及根据受养人数目计算的“残疾退休金”。福利金毋须交税。
申请人可通过My VAC帐户网上申请,亦可下载表格邮寄或亲身递交到退伍军人事务处、加拿大军方过渡中心或加拿大服务处。
(图:Shutterstock)T12
福特与美商务部长通电话 据称加拿大汽车关税将降低
【星岛都市网】安大略省省长道格·福特(Doug Ford)表示,美国商务部长霍华德·卢特尼克(Howard Lutnick)告诉他,美国零部件占50%或以上的加拿大制造汽车将不会面临关税。
美国总统特朗普周三签署了一项行政命令,从下周起对进口到美国的汽车征收25%的关税。
卢特尼克周三晚些时候致电省长福特,表示加拿大将面临不同的税率,但目前尚不清楚加拿大汽车何时能享受关税减免。
由于北美汽车工业的深度一体化,加拿大生产的大多数汽车一半以上的零部件都是由美国制造的。
福特表示,他希望等到4月2日之后再对最新的关税做出回应,届时特朗普将实施他所谓的 “对等”关税,将美国关税提高到与其他国家对进口产品征收的税率相匹配的水平。
加拿大总理马克·卡尼周四中断竞选活动,返回渥太华主持加美关系内阁委员会会议。
T03
特朗普加征进口车关税 法拉利应声涨价!
【星岛都市网】法拉利宣布,因应美国总统特朗普向欧盟汽车加征25%进口关税,部分销往美国的型号将涨价最多10%。
新关税将于4月3日凌晨起生效。法拉利表示,2025年4月2日前进口的所有型号,以及Ferrari 296、SF90和Roma系列的订单价格维持不变。其余型号价格将上调最多10%。
法拉利去年于美国市场的营收占总收入约29%,达16.5亿欧元。公司去年共向美国卖出3,452辆跑车,占总销量25%。法拉利重申维持2025年财务目标,但警告盈利率或下跌50%。
(图:AP)T12
加拿大本周末将有日偏食和“双日出” 安省这些地方可见!
【星岛都市网】周六上午,安大略省一些地区将出现日偏食,但专家表示可能需要离开GTHA地区才能看到。
虽然这次日偏食不会在整个GTHA地区完全可见,但安省东部的一些地区将看到月亮部分遮住太阳的景象,在地平线上形成罕见的效果。
这次日偏食出现在几周前被称为 “血月”的月全食之后。据安大略省科学中心的天文学家 Rachel Ward-Maxwell 称,日月食通常是成对的,每年在两个不同的季节发生。
在 Instagram 查看这篇帖子
Ontario Science Centre (@ontariosciencecentre) 分享的帖子
她说,安大略省将最多看到 35% 的太阳被覆盖,康沃尔和渥太华等城市的覆盖率最高。
当然,这与去年 4 月的日全食有很大不同,当时多伦多居民可以看到约 99.8% 的太阳被遮挡。
虽然日食每隔几年就会发生一次,但Ward-Maxwell强调,像我们去年在 GTHA 看到的日全食“确实是独一无二的,而且更为罕见”。
Ward-Maxwell说:“加拿大东部很多地区都能看到这次日偏食,这将是人们看到月亮从太阳表面掠过的绝佳机会。在安大略省越往西走,看到的机会就越少。”
何时何地可以观看?
专家说,日食将于周六日出时开始,加拿大大西洋地区和努纳武特部分地区将迎来最佳景色。
一些地区的日食覆盖率将超过 90%,但能见度可能因地而异。
被科学记者和业余天文学家Jamie Carter称为 “双日出”的罕见光学幻觉也可能在加拿大部分地区可见。
Ward-Maxwell表示,这将产生 “看起来太阳被月亮分割 ”的效果,但由于安大略省日食覆盖范围有限,这种日食现象在安大略省不太可能看到。
多伦多大学天文学和天体物理学博士生...
全国麻疹病例数持续上升 上周安省增加上百例!
【星岛都市网】安省麻疹病例持续上升,上星期记录上百名新增患者。安省卫生厅表示,去年10月麻疹疫情爆发开始,至今已572例确诊及疑似病例,较3月20日增加102例。当中42人需入院治疗,包括2人入住重症监护室。
西南部及Grand Erie区疫情较为严重,目前疫情已扩散至滑铁卢及Lambton。其中Chatham-Kent区病例于一周内倍增至39例,而Huron Perth地区则有55人感染。其他省份病例较少,阿省记录18例,大部分为未成年人,而魁省维持在40例。
世界卫生组织指出,麻疹是全球最具传染力的疾病之一,病毒可在空气或受感染物表面存活长达两小时。患者初期会出现发烧、咳嗽、流鼻水及红眼等症状,其后面部会出现红疹,并蔓延至身体和四肢。病毒可引起肺炎、脑炎,严重可致命。
(图:AP)T12
警方逮捕11名汽车盗窃嫌犯 全是魁省居民专门来偷车!
【星岛都市网】Durham警方表示,经过数月对一个“有组织汽车盗窃犯罪网络”的调查,逮捕了11名魁北克居民,其中一人因违反释放条件而受到通缉。
警方表示,据信该团伙盗窃了38辆汽车,价值超过250万。
到目前为止,警方表示他们已经寻回了20辆被盗车辆。
Durham地区警察局长Peter Moreira说,嫌疑人面临与调查相关的 160 多项指控。他说,这些指控中有58项涉及涉嫌违反释放令或其他条件,除了三名嫌疑人外,其他嫌疑人都必须遵守这些条件。
另外四名嫌疑人仍未归案。
“这种惯犯行为令人深感不安,”Moreira在宣布逮捕行动的新闻发布会上对记者说。“我不记得上一个被指控犯有这种(汽车盗窃)罪行的人之前是否已经被指控过多次,所以这是令人沮丧的。”
Moreira说,在多伦多地区执行了一系列搜查令后,这些嫌疑人于3月13日被捕。
他说,其中一名嫌疑人后来被释放,并被命令留在蒙特利尔地区的一名担保人那里。然而,四天后,蒙特利尔警方对那所房子进行了合规检查,发现嫌疑人并不在那里。
一段时间后,一名Durham地区警察在Oshawa广场发现了驾驶着白色奔驰车的嫌疑人,并试图将其逮捕。
据称,当时嫌疑人突然倒车并将警察拖行数英尺,然后撞上一辆停着的汽车并逃离现场,整个过程被录像拍了下来。
“这段视频显示了这些人对执法部门的完全蔑视,完全漠视我们社区的安全。幸运的是,涉事警察没有受到严重伤害,不然结果可能会更糟。”
调查于1月份开始
Moreira说,对这一汽车盗窃团伙的调查始于今年1月,当时警方接到报告称Durham地区发生了多起夜间汽车盗窃案。
他说,调查显示,犯罪嫌疑人来到安大略省的唯一目的就是偷车,他们在多伦多的几个地址经营着一个“有组织的”盗窃团伙。
Moreira说,在大多数盗窃案件中,嫌疑人强行进入停放的车辆,然后使用电脑设备重新编程钥匙,然后用钥匙启动汽车并开走。
他说,整个过程只需“几分钟”即可完成。
“这是有组织犯罪。边界对他们来说毫无意义。这里有高价值的盗窃目标,他们就会这样做。”Moreira说。
编译:YUAN
图片:CP24
青年约未成年人烈市见面 涉嫌非礼被捕
【星岛都市网】有Pickering青年涉嫌在社交媒体上邀约未成年人,见面后涉嫌非礼被捕。
警方拘捕19岁的青年Abraar Shaikh,指他在去年10月在年轻人社交平台上和事主倾谈数日,两人其后在烈治文山见面。被告涉嫌在10月21日和事主见面时将事主载到其他地点非礼,其后被捕。
案件将交由法庭审理。警方相信可能有更多受害人,呼吁他们挺身而出。据悉被告在社交平台上以“Aria”及“Aria_abu416”为名,市民如有相关资料可向警方或匿名举报热线提供消息。
(图:约克区警方)T12
官宣!国航北京多伦多直飞航班开始售票 5月20日首航!
【星岛都市网】喜大普奔!多伦多华人期盼已久的北京多伦多直飞航班增加终于有消息了!
自5月20日起,国航正式开通每周两班的北京-多伦多航线,逢每周二、六飞,国航APP现在已经开始售票!
具体航班信息如下:
航班号:CA993 航线:北京首都-多伦多 航班时刻:12.30-13.10
航班号:CA994 航线:多伦多-北京首都 航班时刻:16.15-18.15+1
同时,自5月19日起,国航北京-温哥华调整至每周一CA991/2、周五CA997/8飞行。据此前的班次有所减少,周二、周六的航班取消,只保留了周一、周五的航班。
据国航温哥华营业部消息,所有被取消的航班旅客将自动保护至前一天航班。乘客如不满意自动保护,可非自愿变更一次或退票:
1.改签手续费和票价差额(子舱位差额)或退票手续费可予以免除。
2.可变更至天前或延后一周以内航班(以原出行日期为基准),须在航班起飞前48小时内完成改签。
有网友昨晚表示“本来我预定的是5月24日多伦多-温哥华-北京。昨晚国航客服给我打电话,告知温哥华-北京航班日期有调整、可以免费改签多伦多直航北京的机票。今天折腾了一上午终于改签成功、目前看只有我一个乘客~”
海航目前每周还运营1班北京首都-多伦多航线,每周日执飞,航班信息如下:
航班号:HU7975 航线:北京首都-多伦多 航班时刻:14.35-15.15
航班号:HU7976 航线:多伦多-北京首都 航班时刻:17.20-18.30+1
网友评论:
“买了暑假往返,去程14h回程12h40”
“12h飞多伦多 这个可以啊”
“好贵啊现在看”
“两大一小 5.2w往返好刺激”
“暑假票价还是很肉疼啊,但小时数是真的感人”
“和去年比已经很感人了”
不着急回国的,可以等暑假旺季过后价格下降些再购票!
期待更多好消息!
(YUAN、图片:官网)